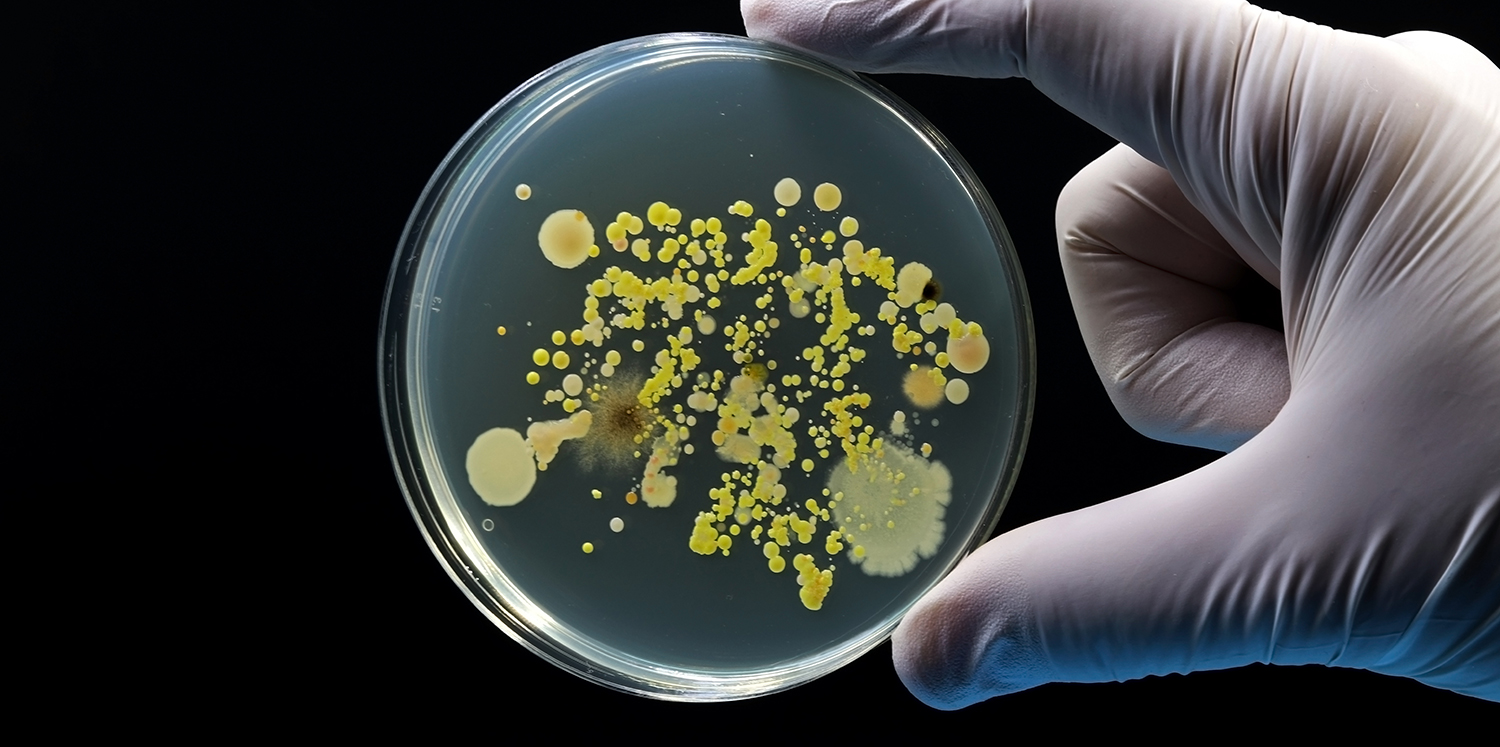

Quality Improvement Resources
MSTCVS‑QC is committed to improving the quality of cardiothoracic care across the state of Michigan. As part of this mission, we provide information and support to help hospitals and clinical teams strengthen their improvement efforts and deliver high‑quality patient care.
Our Quality Improvement Resources offer materials that help teams understand and apply key QI concepts and indicators. These include guidelines, best‑practice information, peer‑reviewed literature, and tools for learning improvement methods such as the PDSA cycle. Together, these resources assist clinicians, perfusionists, data managers, and quality leaders as they enhance processes and contribute to ongoing statewide quality‑improvement initiatives.
Michigan Quality Indicator Resources
Prev
Next

Multiple Arterial Grafting
- Recommendations and Best Practices for Radial Artery Use in Coronary Artery Bypass Grafting

Readmisson
- MSTCVS-QC Readmission Reduction Practices
- Phase of Care Evaluation of Readmissions (POCER) Form
- STS 30 Day Call Back Form, September 2018
McLaren Macomb - Phase of Care Evaluation for Readmission, July 2017 - Margaret Glemblocki DNP, Donna Bonaldi-Swan RN, Henry Ford Macomb
- Cardiac Surgery Post-Op Assessment, July 2017
McLaren Flint - Reducing Cardiac Surgery Readmissions Panel, July 2017
- Readmission after Cardiac Surgery, November 2015
Kourosh Baghelai, MD, Lakeland Health - Reducing 30 Day Readmissions in Cardiac Surgery, November 2015 - DiAnn Stickney, RN, MSN, CRNFA, McLaren Macomb

Atrial Fibrillation Surgical Treatment Guideline
- The Society of Thoracic Surgeons 2023 Clinical Practice Guidelines for the Surgical Treatment of Atrial Fibrillation
- Concomitant Surgical Ablation in Paroxysmal vs Persistent Atrial Fibrilllation During Mitral Surgery, Long-Tern Survival Benefit of Surgical Atrial Fibrillation in Mitral Surgery
- Surgical Atrial Fibrillation Ablation Improves Long-Term Survival: A Multicenter Analysis
- The Society of Thoracic Surgeons 2017 Clinical Practice Guidelines for the Surgical Treatment of Atrial Fibrillation - Annals of Thoracic Surgery; January 2017
- 2017 HRS/EHRA/ECAS/APHRS/SOLAECE expert consensus statement on catheter and surgical ablation of atrial fibrillation - Heart Rhythm, Vol 14, No 10, October 2017
- 2016 ESC Guidelines for the management of atrial fibrillation developed in collaboration with EACTS - European Journal of Cardio-Thoracic Surgery, Volume 50, Issue 5, November 2016, Pages e1–e88

Post Operative Atrial Fibrillation
- MSTCVS QC Atrial Fibrillation Prophylaxis Practices
- MidMichigan Health Center's A-fib Prophylaxis Protocol - Robert Jones, MD; 2011 Annual Summer Conference

Postoperative Renal Failure Prevention
- MSTCVS-QC Protocols for Prevention of Post-Operative Renal Failure
- A Turnkey Order Set for Prevention of Cardiac Surgery–Associated Acute Kidney Injury

Postoperative Prolonged Ventilation Prevention
- Recommendations and Best Practices for Early Extubation Following Cardiac Surgery
- ICU Hand-off and Extubation Checklist
University of Washington - U of M Hand-off communication tool
- MSTCVS Vent Weaning Recommendations

Appropriate Pre Operative and Discharge Medications

Pneumonia Prevention
- Preventing Post-operative Pneumonia Following CABG Surgery - The Role of Pulmonary Disease - Video
- Pneumonia Prevention Recommendations
Postoperative Wound Infection Prevention
- Prevention and management of sternal wound infections - Harold L Lazar, MD - Division of Cardiac Surgery, Boston Medical Center; 2016 The American Association for Thoracic Surgery
- Recommendations to Reduce Sternal Wound Infection - February 2014; Donna Bonaldi-Swan, RN, Henry Ford Hospital

Reducing Net Prime Volume
- Greater Volume of Acute Normovolemic Hemodilution May Aid in Reducing Blood Transfusions After Cardiac Surgery
- Net Prime Volume Is Associated with Increased Odds of Blood Transfusion

Intraoperative Glucose Management

Increasing Cardiotomy Suction Termination Prior to Protamine Administration
- Protamine Test Dose: Impact on Activated Clotting Time and Circuit Integrity
- Advancing cardiotomy suction practices for coronary surgery via multidisciplinary collaborative learning

Change-Out Oxygenators In Under Four Minutes
- Change-Out Oxygenators In Under Four Minutes

Mortality
- Guide to Phase of Care Mortality Analysis (POCMA)
- A Method to Evaluate Cardiac Surgery Mortality: Phase of Care Mortality Analysis
- Cardiac Surgery Phase of Care Mortality Analysis (POCMA) Form – PDF Format
- Cardiac Surgery Phase of Care Mortality Analysis (POCMA) Form – Word Format
- TAVR Phase of Care Mortality Analysis (POCMA) Form - PDF Format

Blood Conservation

Perioperative Care
- The Society of Thoracic Surgeons Expert Consensus Document on the Management of Pleural Drains After Pulmonary Lobectomy - The Annals of Thoracic Surgery
- The Society of Thoracic Surgeons Practice Guideline on the Prophylaxis and Management of Atrial Fibrillation Associated With General Thoracic Surgery: Executive Summary - The Annals of Thoracic Surgery
- The Society of Thoracic Surgeons Expert Consensus on the Multidisciplinary Management and Resectability of Locally Advanced Non-Small Cell Lung Cancer

Lymph Node Sampling
- Commission on Cancer Standard 5.8: Requirements & Best Practices
- Best Practices for Guideline-Concordant Lymph Node Sampling In Lung Cancer Surgery

Esophageal Cancer
- Multimodality Therapy for Locally Advanced Cancer of the Esophagus or Gastroesophageal Junction

Thymoma
- The Society of Thoracic Surgeons Expert Consensus Document on the Surgical Management of Thymomas






